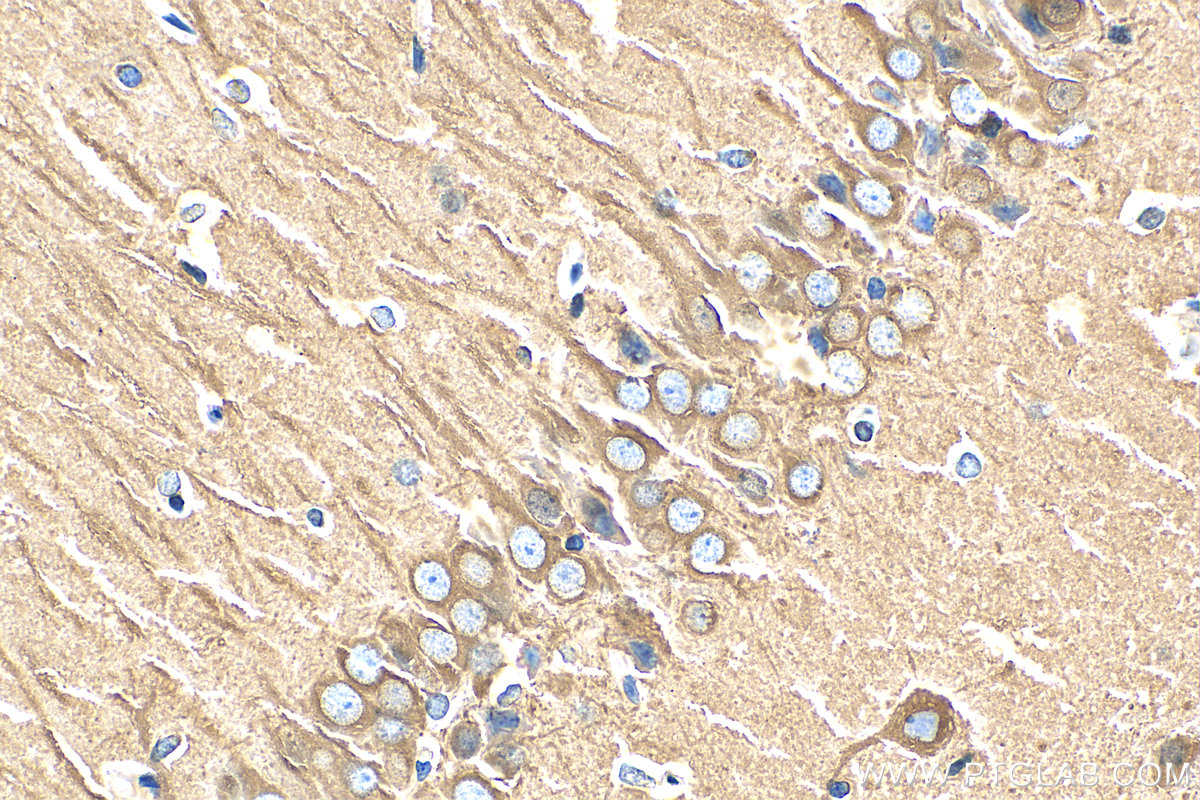

验证数据展示
经过测试的应用
| Positive WB detected in | HeLa cells, HEK-293 cells, zebrafish tissue, Jurkat cells, K-562 cells, Hsc-T6 cells, NIH/3T3 cells, mouse brain, rat brain |
| Positive IP detected in | HEK-293 cells |
| Positive IHC detected in | human colon tissue, rat brain tissue Note: suggested antigen retrieval with TE buffer pH 9.0; (*) Alternatively, antigen retrieval may be performed with citrate buffer pH 6.0 |
| Positive IF-P detected in | mouse eye tissue |
| Positive IF/ICC detected in | C2C12 cells, HeLa cells, HepG2 cells |
| Positive FC (Intra) detected in | HEK-293 cells |
推荐稀释比
| 应用 | 推荐稀释比 |
|---|---|
| Western Blot (WB) | WB : 1:5000-1:50000 |
| Immunoprecipitation (IP) | IP : 0.5-4.0 ug for 1.0-3.0 mg of total protein lysate |
| Immunohistochemistry (IHC) | IHC : 1:500-1:2000 |
| Immunofluorescence (IF)-P | IF-P : 1:50-1:500 |
| Immunofluorescence (IF)/ICC | IF/ICC : 1:250-1:1000 |
| Flow Cytometry (FC) (INTRA) | FC (INTRA) : 0.20 ug per 10^6 cells in a 100 µl suspension |
| It is recommended that this reagent should be titrated in each testing system to obtain optimal results. | |
| Sample-dependent, Check data in validation data gallery. | |
产品信息
80713-1-RR targets Beta Tubulin in WB, IHC, IF/ICC, IF-P, FC (Intra), IP, ELISA applications and shows reactivity with human, mouse, rat, zebrafish samples.
| 经测试应用 | WB, IHC, IF/ICC, IF-P, FC (Intra), IP, ELISA Application Description |
| 文献引用应用 | WB, IF |
| 经测试反应性 | human, mouse, rat, zebrafish |
| 文献引用反应性 | human, mouse, rat, pig, zebrafish |
| 免疫原 |
CatNo: Ag0117 Product name: Recombinant human Tubulin-beta protein Source: e coli.-derived, PGEX-4T Tag: GST Domain: 44-259 aa of BC000748 Sequence: LERISVYYNEASSHKYVPRAILVDLEPGTMDSVRSGAFGHLFRPDNFIFGQSGAGNNWAKGHYTEGAELVDSVLDVVRKECENCDCLQGFQLTHSLGGGTGSGMGTLLISKVREEYPDRIMNTFSVVPSPKVSDTVVEPYNATLSIHQLVENTDETYCIDNEALYDICFRTLKLATPTYGDLNHLVSATMSGVTTSLRFPGQLNADLRKLAVNMVP 种属同源性预测 |
| 宿主/亚型 | Rabbit / IgG |
| 抗体类别 | Recombinant |
| 产品类型 | Antibody |
| 全称 | tubulin, beta 3 |
| 别名 | Tubulin beta 3 chain, Tubulin beta III, β III tubulin , βIII tubulin , 2O13 |
| 计算分子量 | 450 aa, 50 kDa |
| 观测分子量 | 50-55 kDa |
| GenBank蛋白编号 | BC000748 |
| 基因名称 | TUBB3 |
| Gene ID (NCBI) | 10381 |
| RRID | AB_2918906 |
| 偶联类型 | Unconjugated |
| 形式 | Liquid |
| 纯化方式 | Protein A purification |
| UNIPROT ID | Q13509 |
| 储存缓冲液 | PBS with 0.02% sodium azide and 50% glycerol, pH 7.3. |
| 储存条件 | Store at -20°C. Stable for one year after shipment. Aliquoting is unnecessary for -20oC storage. |
背景介绍
There are five tubulins in human cells: alpha, beta, gamma, delta, and epsilon. Tubulins are conserved across species. They form heterodimers, which multimerize to form a microtubule filament. An alpha and beta tubulin heterodimer is the basic structural unit of microtubules. The heterodimer does not come apart, once formed. The alpha and beta tubulins, which are each about 55 kDa MW, are homologous but not identical. Alpha, beta, and gamma tubulins have all been used as loading controls. Tubulin expression may vary according to resistance to antimicrobial and antimitotic drugs.
实验方案
| Product Specific Protocols | |
|---|---|
| FC protocol for Beta Tubulin antibody 80713-1-RR | Download protocol |
| IF protocol for Beta Tubulin antibody 80713-1-RR | Download protocol |
| IHC protocol for Beta Tubulin antibody 80713-1-RR | Download protocol |
| IP protocol for Beta Tubulin antibody 80713-1-RR | Download protocol |
| WB protocol for Beta Tubulin antibody 80713-1-RR | Download protocol |
| Standard Protocols | |
|---|---|
| Click here to view our Standard Protocols |
发表文章
| Species | Application | Title |
|---|---|---|
Int Immunopharmacol Fibrinogen drives neuroinflammation and neuropathology in perioperative neurocognitive disorders. | ||
Front Pharmacol Multi-omics reveal the neuroprotective mechanisms of Xinshubao tablet against scopolamine-induced cognitive dysfunction in mice | ||
Exp Neurol Integrative multi-omics and machine learning identify CALR as a diagnostic and therapeutic target in aneurysmal subarachnoid hemorrhage | ||
Med Gas Res Mechanism by which hydrogen-rich water mitigates exercise-induced fatigue: activation of the immunoresponsive gene 1-itaconate/nuclear factor erythroid 2-related factor 2/heme oxygenase-1 pathway | ||
Adv Healthc Mater Accurate Neurotransmitter Release by Ultrasound-Responsive Nanomaterials for Alleviating L-DOPA-Induced Dyskinesia in Parkinson's Disease | ||